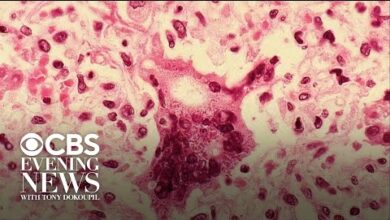

Confirmed
-
News
Fact Check: “50 Nursing Students” Measles Claim Is False—Florida School Outbreak Confirmed
Recent social media posts and news headlines have circulated claiming that “over 50 nursing students” were infected in a measles…
Read More »